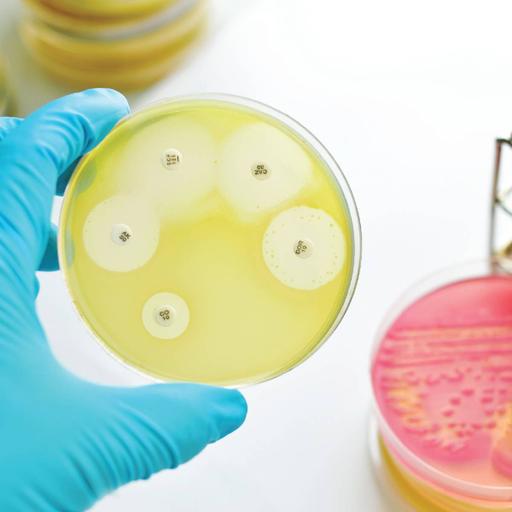
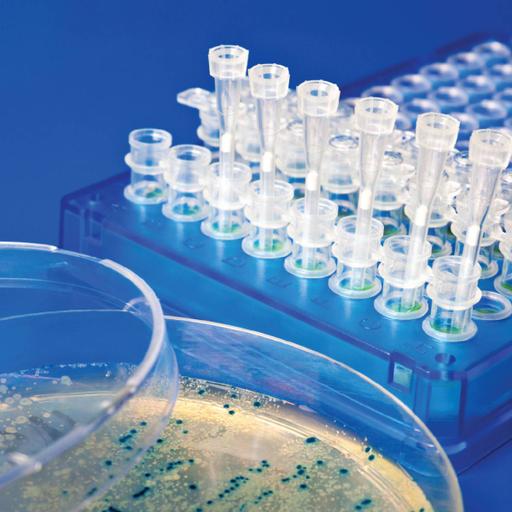

Disciplined, planned and organized in her work, Preena uses smart and simple language in her writing that informs the reader about the subject and also keeps them engaged in the content. A well thought out plan and discipline in execution is her key quality for content writing.